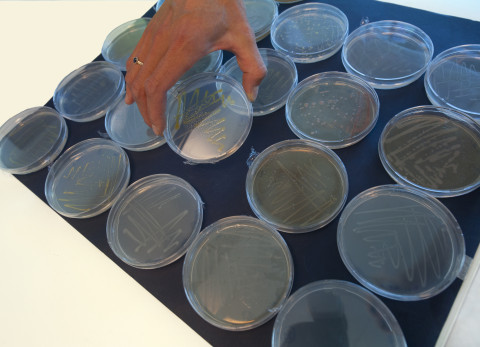
ME lab platen

Ook micro-organismen kunnen samenwerken en rewilden
Ook micro-organismen kunnen samenwerken en rewilden
Perscontact
Van nietige losse cellen naar een rijke gemeenschap vol samenwerking. Dat is hoe het inzicht in de microwereld van bacteriën, schimmels en andere microscopisch kleine organismen zich de afgelopen twee decennia ontwikkeld heeft. Dit ‘microbioom’ op bijvoorbeeld blad en wortel en in darm en bodem heeft een enorme impact op de omgeving. Onderzoekers van het Nederlands Instituut voor Ecologie (NIOO-KNAW) kijken naar functies zoals ‘consumeren’ van broeikasgas, communicatie via geuren en hulp aan bedreigde planten.
‘Tien tot twintig jaar geleden onderzocht je feitelijk enkele, losse microben’, vertelt Jos Raaijmakers. Sinds 2014 is hij afdelingshoofd Microbiële Ecologie bij het NIOO. Raaijmakers heeft gezien hoe de onderzoekstechnieken zich sindsdien razendsnel hebben ontwikkeld. Die vernieuwing begon met het via DNA-codes in kaart brengen van de hele gemeenschap, in plaats van die van enkele cellen en een beperkt aantal soorten. ‘Het leek toen nog op postzegels verzamelen: welke soorten zitten er? Eindelijk konden we daar meer over te weten komen, want verreweg de meeste micro-organismen zijn niet te kweken in het lab. Inmiddels richten we ons veel meer op wat die micro-organismen doen. En vooral wat ze sámen doen.’ Dat is mogelijk geworden door steeds geavanceerdere methoden van sequencen: het aflezen van de DNA-codes kan nu bijna direct uit bijvoorbeeld een monster van een bodem of een blad.
Een eigen jas
Elke plek heeft een eigen microbiële gemeenschap: een eigen microbioom dus. Zo heeft een blad van een plant een hele jas van bepaalde soorten bacteriën en schimmels, de ‘fyllosfeer’. Bij het blad van een andere plant, rond wortels (in de ‘rhizosfeer’) of in darmen vind je weer een heel andere samenstelling. Raaijmakers: ‘Er zijn maar weinig soorten die overal aarden.’ Hoewel schimmels en bacteriën nog steeds een slechte naam hebben, hebben de meeste juist neutrale of zelfs goede eigenschappen. Slechts een klein deel is ziekteverwekker, en dat hangt ook nog eens van de situatie af.
‘Alle organismen zijn volledig bedekt met microben. Het interessante is dat iedereen aanneemt dat die altijd een functie hebben. Maar uit onderzoek blijkt dat alleen in sommige gevallen sprake is van een aantoonbare functie voor de gastheer.’ Om daar achter te komen bij planten, kun je ze kweken in aan- en afwezigheid van het bijbehorende microbioom. De groei, de weerstand tegen ziektes en de wortelarchitectuur geven aanwijzingen van de effecten die de micro-organismen op de plant hebben. Dat is niet zwart-wit. ‘Ze kunnen misschien maar 5 procent van de uiteindelijke verschijningsvorm van de plant bepalen, en in een ander geval bijvoorbeeld 30 procent. En soms helemaal niet: dan zijn het de plantengenen die hun stempel drukken. Hier valt nog een hele puzzel te leggen.’ Raaijmakers betoogt dat dit eigenlijk altijd het startpunt voor onderzoek aan een specifiek microbioom zou moeten zijn. ‘Als het microbioom maar een heel kleine rol blijkt te hebben, is het dan verder onderzoek wel waard?’
Klassiek & modern
Terug naar het begin: hoe is het microbiële onderzoek begonnen? De klassieke aanpak bestaat uit het isoleren van vooral bacteriën en schimmels uit het milieu, legt microbieel ecoloog Paul Bodelier uit. ‘Je kijkt wat er gaat groeien op een bepaalde voedingsplaat in het lab en daar selecteer je losse kolonies van een soort uit. Met deze “isolaten” kun je vervolgens testen wat ze allemaal kunnen. We hebben intussen een enorme collectie isolaten opgebouwd.’ De DNA-technieken die het mogelijk maken om de micro-organismen te zien als een gemeenschap, vergden in het begin veel uitproberen. De techniek van PCR (polymerase chain reaction) kwam uit het fundamentele DNA-onderzoek, maar bleek begin jaren 1990 erg belangrijk voor de ecologie. Daarom startte het NIOO toen een eigen DNA-lab. ‘Door het zogenaamde “16S”-gen te vermenigvuldigen met PCR, kun je kijken welke micro-organismen er allemaal in je monster zitten. Het ging toen nog om de diversiteit aan soorten. Je zag eigenlijk alleen wat je kende, want dat vermenigvuldigde je met PCR.’
Langzamerhand zijn de ecologen naar de rest van het DNA gaan kijken, op zoek naar functionele genen die vertellen wat micro-organismen allemaal kunnen. De eerste “genomen”, de complete genetische code van organismen, kwamen beschikbaar. De volgende stap was die van de metagenomen: de code van een hele gemeenschap in bijvoorbeeld een handje bodem. Hiervoor waren steeds betere sequence- en analysemethoden nodig en die kwamen er.
‘Met shotgun metagenomics schiet je het DNA in je bodemmonster in kleine stukjes om vervolgens daar de code van af te lezen. Met speciale programma’s kun je die weer virtueel aan elkaar plakken tot hele genomen, en daar zit van alles tussen dat we nog niet uit een van de genoomdatabanken kenden. We kunnen nu veel meer microben karakteriseren, ook soorten die we niet konden kweken in het lab. Dus we hebben echt een beter beeld gekregen van gemeenschappen plus de functies daarvan.’ Dat gaat bij schimmels die veel grotere genomen hebben, overigens veel lastiger dan bij bacteriën.
Hallo!
Voor alle interacties in het microbioom moeten micro-organismen met elkaar communiceren. Hoe werkt dat? Bij de afdeling Microbiële Ecologie doet Paolina Garbeva daar al jaren onderzoek aan. De boodschappen tussen bacteriën onderling (‘kom ook hier naartoe’), maar ook tussen bacteriën en schimmels (‘blijf hier weg, dit eten is van mij’) zitten verpakt in geurstoffen. Via de lucht of via water verspreiden die zich snel.
De communicatiestoffen zijn essentieel in de natuur, maar ook voor de mens heel interessant. Zo komen bijna alle antibiotica die wij gebruiken als medicijn oorspronkelijk van micro-organismen uit de bodem. Dat zijn stoffen die in de natuur voor “chemische oorlogsvoering” worden gebruikt tussen concurrenten. Door in het lab isolaten van verschillende micro-organismen samen te brengen, kun je zulke interacties ontdekken en volgen.
Verder dan plantenziekten bestrijden
‘Eigenlijk is de rode draad van het verhaal, dat we toch altijd weer terugkomen bij de klassieke methode. Ondanks al dat geweld aan DNA-technieken, want dat levert je alleen maar het genetisch materiaal op en het organisme heb je niet in handen’, licht Bodelier toe. En juist als je de functies van micro-organismen wilt testen, kan dat maar op één manier: met het organisme zelf.
Voor de bodem bestaat er vrijwel geen techniek om functies van micro-organismen rechtstreeks in het milieu te meten zonder het te verstoren. De NIOO-onderzoekers combineren nu de klassieke met de moderne route. Eerst DNA-technieken inzetten om te “screenen” wat voor microleven ergens zit, dan klassiek te werk gaan om dat te isoleren en tot slot weer terug naar de veldsituatie om te kijken of het isolaat hetzelfde interessante of gewenste effect geeft als de onderzoeker bij de start zag. Bodelier: ‘Dit onderzoek gaat nu best rap: van begin tot eind in vijf jaar bijvoorbeeld. Bij het Promise-project is dit gelukt.’ Dat project draait om een agrarische toepassing, waar wortelmicroben in de Afrikaanse landen ten zuiden van de Sahara worden ingezet om een ernstig onkruid in de sorghumteelt van kleine zelfvoorzienende boeren te bestrijden.
Het isoleren van micro-organismen gaat nu veel gerichter dan vroeger, waardoor je sneller kunt kijken naar hun eigenschappen en welke daarvan interessant zijn. ‘Het gaat niet meer alleen over toepassingen voor een duurzame landbouw – denk aan plantenziekten bestrijden –, maar ook voor het klimaat, een gezonde bodem en schoon water. Sturen in de goede richting komt steeds meer binnen handbereik. Een organisme gericht toevoegen op een plek is één benadering, maar kijken wat er al in het veld leeft en hoe je dat harder kunt laten werken, is wellicht kansrijker.’
Ecologische vragen
Wat voor grote ecologische vragen kun je dan beantwoorden? Zelf bestudeert Bodelier de micro-organismen die broeikasgassen zoals methaan of lachgas produceren of juist afbreken. Hoe klein ze ook zijn, ze hebben een enorme impact op de wereldwijde broeikasgasproductie. Hij kijkt sinds kort naar de veranderende methaanbalans in de arctische meren van Groenland, en al veel langer naar compost en welke methaan-producerende en vooral methaan-etende bacteriën daar actief zijn. In een nieuw onderzoek gaat compost ook de grond in – met of zonder klei erbij – om te volgen wat er dan gebeurt.
Dit onderzoek heeft een duidelijke link naar het bodembeleid. ‘In de net nieuwe Bodemmonitoringswet van de EU wordt de levende bodem nu eindelijk serieus meegenomen met een integrale aanpak voor een gezonde bodem. Maar nu moet nog het microbiële deel een volwaardige plek krijgen. De schimmel-bacterieverhouding, waarbij je de biomassa van beide groepen vergelijkt, wordt al wel toegepast. In ongestoorde bosbodems waar veel koolstof wordt vastgelegd zie je relatief meer schimmelmassa, en waar koolstof wordt verbruikt door groeiende gewassen zijn er meer bacteriën. Microbiële diversiteit is moeilijker te meten, terwijl die wel achteruitgaat door intensief grondgebruik.’
Wilde microbiomen
Welke rol speelt het microbioom nog meer in ecosystemen? Raaijmakers deed met zijn team onderzoek aan de wilde verwanten van onder andere de tomaat. ‘Doordat het oorspronkelijke bodemmicrobioom van wilde voorouderplanten niet meer aanwezig is bij het doorgekweekte gewas, worden deze planten veel gevoeliger voor insecten.’ Deze kennis kan waardevol zijn voor het verduurzamen van de landbouw, maar het vertelt ons ook het nodige over de rol van het microbioom in natuurlijke ecosystemen. Denk bijvoorbeeld aan de herintroductie van plantensoorten en het beheer van uit productie genomen landbouwgronden.
‘Sinds een jaar of drie zijn er interessante ontwikkelingen in ecologische ecosysteemrestoratie’, vertelt Raaijmakers. ‘Zeker bij planten kun je het microbioom meenemen. De kieming en vestiging van bedreigde plantensoorten verbetert daardoor. Zo kun je in de eerste, meest gevoelige periode de kansen voor de planten verhogen.’ De rewilding van het microbioom kun je zo doorvoeren naar de rewilding van het hele ecosysteem: wil je een boom- of andere plantensoort terugbrengen, dan is daarbij ook het bijpassende microbioom nodig. ‘Als je de juiste combinatie van micro-organismen meegeeft waarmee ze evolutionair gezien goede allianties hebben, geef je die planten een voorsprong.’ Je voorziet ze van ‘microbiële vrienden.’
Bodemonderzoekers van het NIOO hebben dit toegepast in de natuur. Met bodemtransplantatie lieten ze zien dat de micro-organismen in donorgrond uit gezonde heide- of andere natuurgebieden minder gezonde grond snel kunnen verbeteren. En in de bakken met ‘Ecosystemen van de Toekomst’ van de NIOO-proeftuinen staan planten centraal die door klimaatverandering zonder microbiële vrienden en vijanden verhuizen naar noordelijker streken. Gaan zij woekeren, en krijg je uiteindelijk weer hetzelfde of juist een nieuw ecosysteem?
Wat nog te onderzoeken?
‘Graag zou ik de functies van de organismen in het microbioom nog verder zichtbaar maken’, deelt Raaijmakers. ‘Er zijn genetische eigenschappen die je in het lab nu nooit te zien krijgt, maar in de natuur wél. Welke triggers zijn er nodig om die toch “aan” te zetten bij het labonderzoek?’ ‘Het microbioom-onderzoek heeft een enorme vlucht genomen. We hebben nu wel “succesverhalen” nodig die de mogelijkheden voor natuurherstel of duurzame landbouw praktisch en zichtbaar maken. Als je daadwerkelijk pesticiden en ander gebruik van chemische stoffen wilt verminderen, dan moet je weten hoe je de samenstelling van het microbioom consistent kunt toepassen.’ Raaijmakers vertelt verder dat je ‘met wat tegenwoordig synthetische communities van micro-organismen heet een gewenste uiterlijke verschijningsvorm van een plant – goed groeiend of niet ziek bijvoorbeeld – kunt reconstrueren, die gekoppeld is aan dat microbioom. Er zitten daar dan tussen de vijf en zestig verschillende soorten microben in. Er is namelijk niet maar één silver bullet, niet maar één soort micro-organisme dat gewassen of wilde planten beschermt tegen alles. Het is duidelijk een team.’
Wat leeft er nog meer?
Bacteriën en schimmels vormen de hoofdmoot van het microbiële onderzoek. ‘We weten niet hoeveel soorten er precies zijn, maar inmiddels wel dat het er heel veel zijn. Van de bacteriën bijvoorbeeld is naar schatting nog maar 1 procent van de soorten bekend en beschreven. Dat betekent dat er in totaal wel meer dan een miljard zijn’, licht Bodelier toe. Alleen al in een gram grond leven miljarden micro-organismen, een paar duizend soorten bacteriën en schimmels. Maar ook de nodige andere organismen hebben hun plek in het microbioom.
De buitenbeentjes die we vaak vergeten, zijn de virussen (zie kader op pagina 15). Verder zijn er protozoa – allerlei soorten eencelligen tot ‘mini-roofdiertjes’ aan toe – en Archaea. Eerder werden die versleten voor oerbacteriën, omdat ze daar oppervlakkig op lijken. Inmiddels weten we dat ze een eigen groep vormen, waar ook de mens van afstamt. Omdat ze erg moeilijk kweekbaar zijn en erg langzaam groeien, vindt er niet veel onderzoek aan plaats. De beste naam hebben de gisten. Dankzij brood en bier hebben ze een veel betere PR dan micro-organismen in het algemeen. Viviane Cordovez kijkt met haar onderzoeksgroep naar gisten op bladeren. Kan een mengsel van gunstige gisten ziekten onderdrukken bij tarwe? Parasitaire Fusarium-schimmels – die ze ‘cereal killers’ gedoopt hebben – kunnen ze wellicht onder de duim houden. Een andere tak van het onderzoek kijkt naar de onzichtbare biodiversiteit op de Galapagoseilanden. Het doel is niet alleen om de evolutie van de verschillende soorten micro-organismen beter te begrijpen, maar ook van de planten waar ze op leven. Kennis over de bedreigde inheemse ‘reuzenmadeliefjes’ en hun onbekende microbiële vrienden kan hopelijk helpen om deze planten te beschermen.
Vergeten virussen
‘In veel natuuronderzoek en -beheer worden planten, dieren en microben standaard meegenomen, maar virussen niet’, stelt virusonderzoeker Mark Zwart. ‘Terwijl ze wel degelijk een rol spelen in de gezondheid, de dynamiek en uiteindelijk ook de veerkracht van ecosystemen.’ De aandacht was historisch vooral gericht op ziekteverwekkers van mens, gewas en vee. Maar alle soorten – van planten tot insecten, schimmels en zoogdieren – dragen virussen bij zich en een virusinfectie leidt lang niet altijd tot ziekte. In verschillende gevallen lijken ze juist gunstige effecten te hebben, zoals een verhoogde droogteresistentie bij planten. ‘En zelfs wanneer virussen wél ziekte veroorzaken, kan het effect op ecosysteemniveau positief uitpakken. Virussen kunnen bijvoorbeeld de diversiteit in microbiële gemeenschappen waarborgen door de snelst groeiende soorten af te remmen.’
Wat Zwart bezighoudt, is dat we voor planten en dieren heel goed weten waar ze voorkomen en waarom dat zo is, maar voor virussen vrijwel niet. ‘Ik wil graag begrijpen hoe virussen zich ontwikkelen en verspreiden in natuurlijke ecosystemen, en hoe virusgemeenschappen veranderen in ruimte en tijd. En wat dat betekent voor de evolutie en veerkracht van ecosystemen.’
Hoe leg je die verborgen viruswereld bloot? Virussen zijn kleiner dan klein. Het zijn minuscule parasieten die alleen maar bestaan uit wat genetisch materiaal in een eiwitomhulsel. Tegenwoordig kan met moderne sequencing-technieken in één keer in kaart worden gebracht welke virussen er aanwezig zijn in een organisme of omgeving: het viroom. Toch gaat dat nog niet zo makkelijk. ‘Voor bacteriën en schimmels bestaan kant-en-klare methoden om hun gemeenschappen te karakteriseren, maar voor virussen is dat technisch veel lastiger door hun enorme genetische diversiteit. Daardoor is vaak moeilijk te herkennen welk erfelijk materiaal werkelijk van virussen afkomstig is.’ Inmiddels kan je daar wel analyses met machine learning voor inzetten, die gebruikmaken van kennis over viruskenmerken of voor ons onzichtbare patronen herkennen. ‘Hierdoor kunnen we nu virussen detecteren die we vroeger gemist zouden hebben. Bovendien kunnen we viroom-data met nieuwe statistische methoden koppelen aan ecologische gegevens, zoals bodemtype, plantensoort of seizoen.
Dit is het negende en laatste artikel in een serie over 70 jaar ecologisch onderzoek van het Nederlands Instituut voor Ecologie (NIOO-KNAW). In elke aflevering stond een andere onderzoekslijn centraal. Kijk hier voor meer over 70 jaar ecologie.
Dit artikel verscheen ook in het decembernummer van Vakblad Natuur Bos Landschap.









